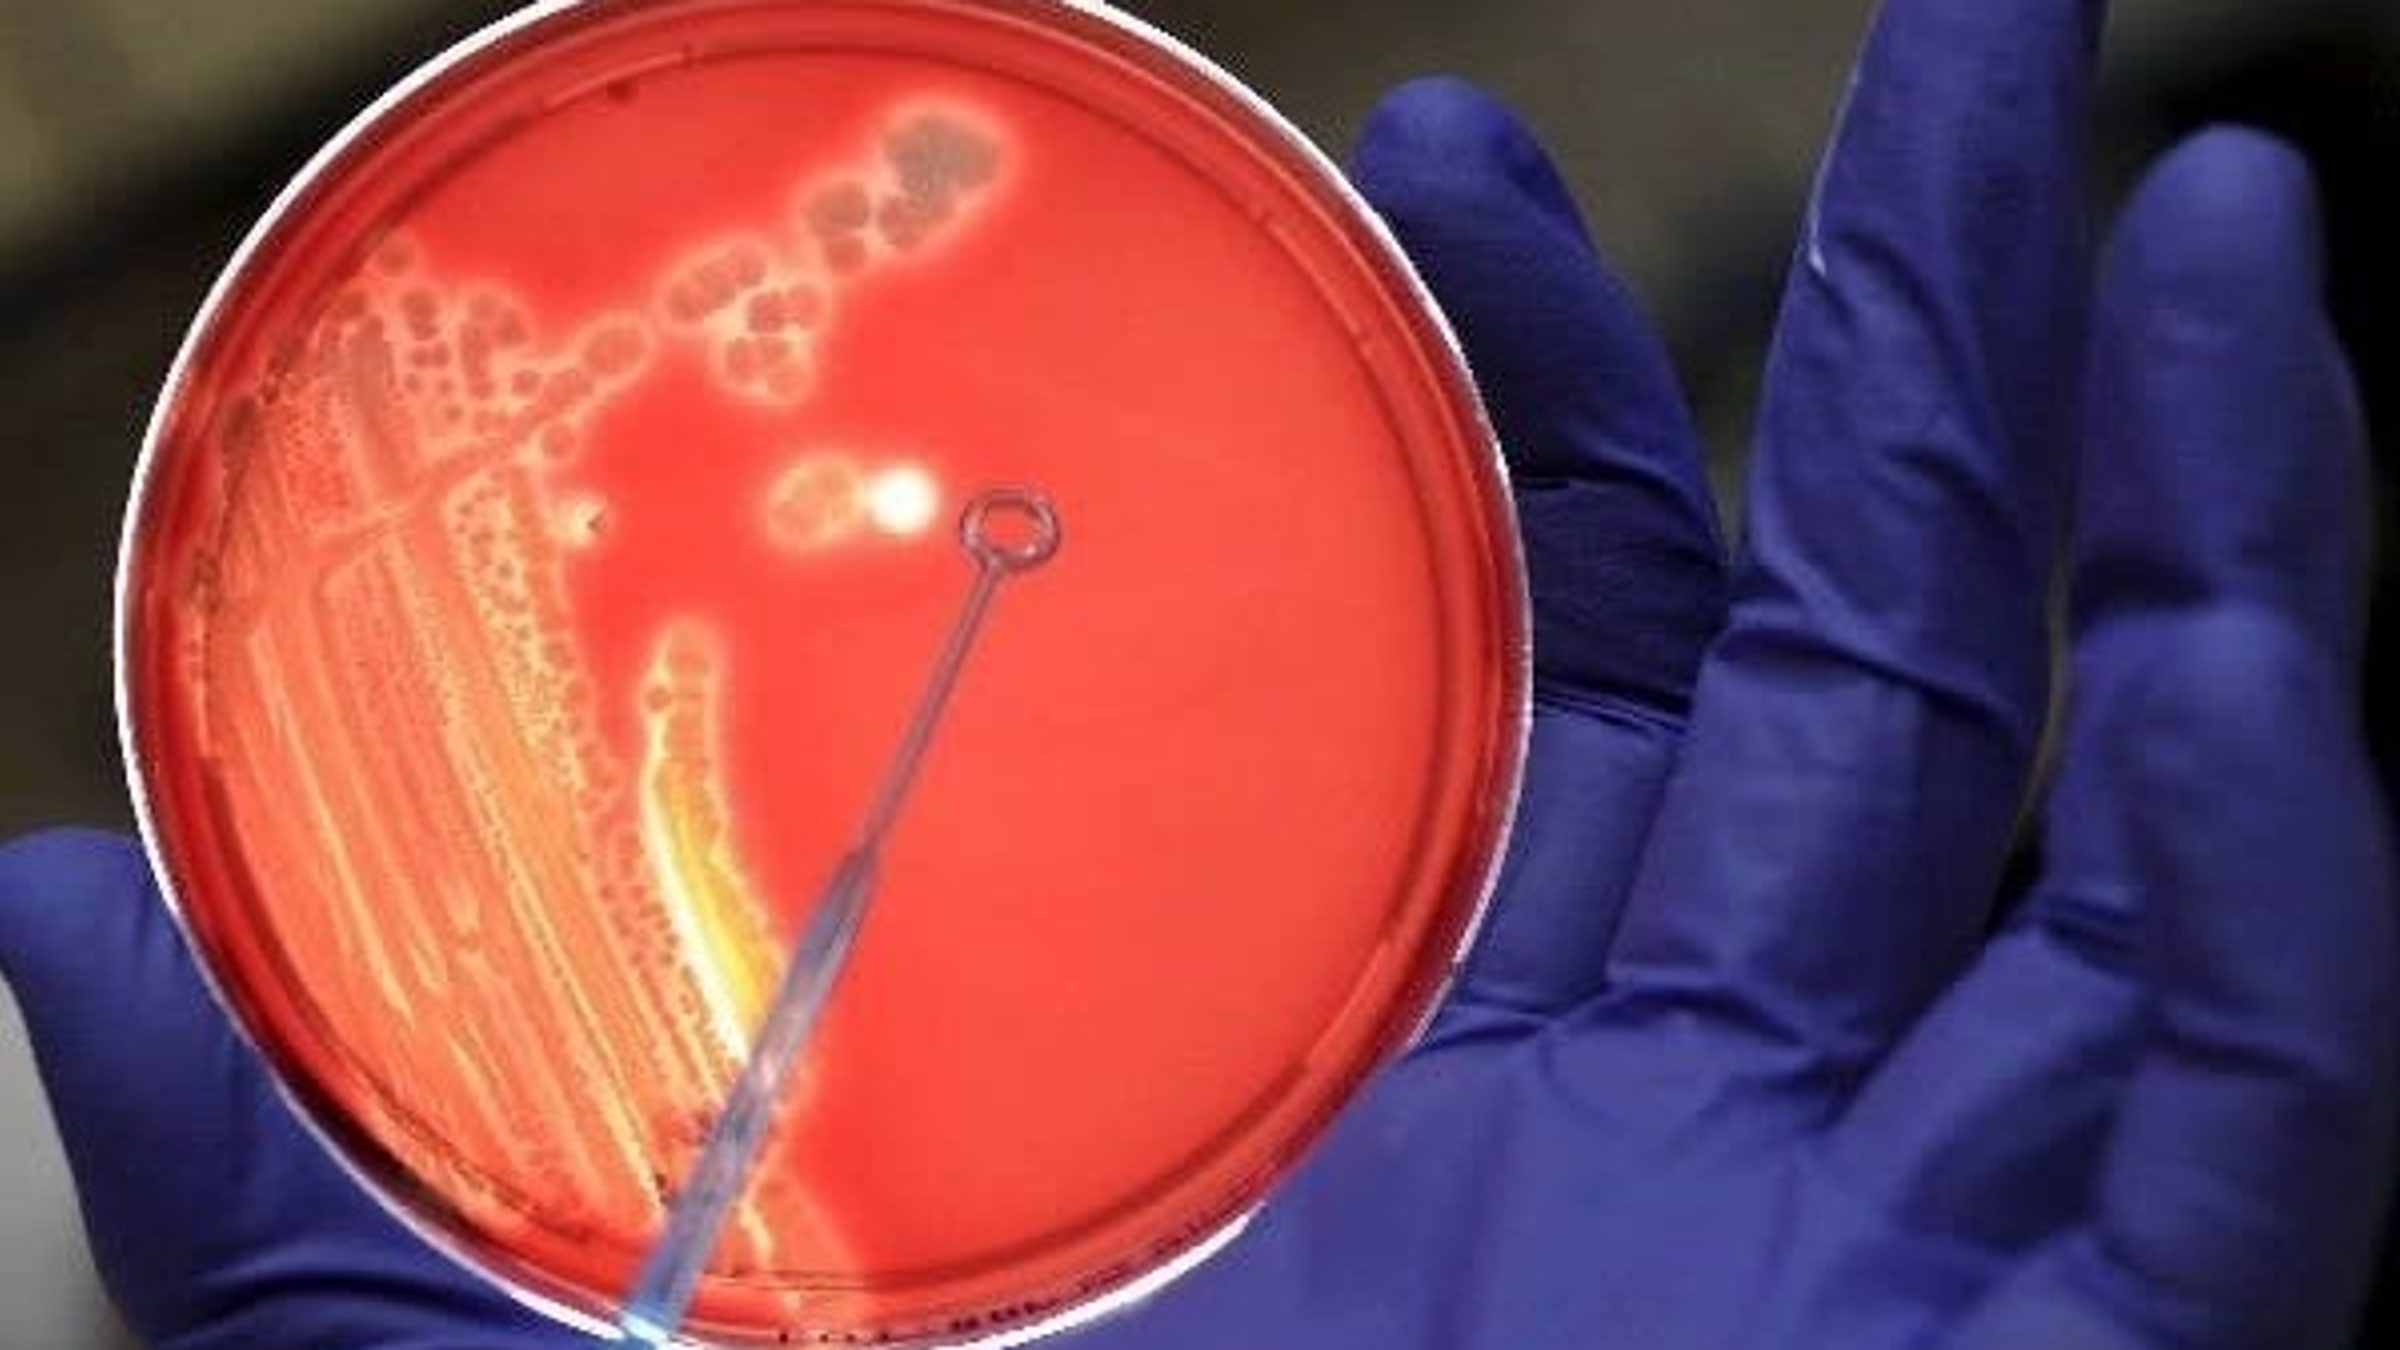

Entre 2018 y 2023, la resistencia de las bacterias a los antibióticos, a menudo fruto del mal uso de éstos, ha aumentado un 40 %, o un promedio anual de entre el 5 % y el 15 %, advierte la Organización Mundial de la Salud (OMS), que considera este fenómeno una de las grandes amenazas sanitarias del futuro.
Según los últimos datos reportados este lunes por GLASS, el sistema de supervisión de resistencia a los antimicrobianos de la OMS, una de cada seis infecciones de las bacterias a las que esta red está haciendo un seguimiento mostraron resistencia a tratamientos con antibióticos.
La situación es especialmente alarmante en regiones como África, donde una de cada cinco infecciones mostró resistencia a los antibióticos, o en Asia y Oriente Medio, donde la tasa es de una de cada tres.
Más rápido que los avances clínicos
Para el estudio se testaron 22 antibióticos utilizados comúnmente para infecciones del tracto urinario, el gastrointestinal, el sistema sanguíneo o para tratar la gonorrea.
En él se pone a prueba la resistencia de ocho bacterias igualmente frecuentes en ese tipo de infecciones, entre ellas la E.coli, la salmonela, el estafilococo aureus o el estreptococo pneumoniae.
“La resistencia a los antimicrobianos está creciendo a un ritmo más rápido que los avances de la medicina moderna”, advirtió al presentarse el estudio el director general de la OMS, Tedros Adhanom Ghebreyesus.
Esa resistencia a antimicrobianos, que incluye la de bacterias a antibióticos pero también la de virus a antivirales o la de hongos a los fungicidas, influye en casi 5 millones de muertes anuales por infecciones, y se considera causa directa en 1,27 millones de casos, según los datos de la OMS.
Las dos bacterias más resistentes
Las bacterias que según la agencia sanitaria de la ONU están mostrando cada vez mayor resistencia a los antibióticos son la E.coli y la Klebsiella pneumoniae, dos de los patógenos con mayor riesgo de infecciones graves.
Más del 40 % de las bacterias E.coli estudiadas y un 55 % de las K.Pneumoniae son resistentes a cefalosporinas de tercera generación, el antibiótico más habitual para responder a las infecciones que causan.
La resistencia a antibióticos de amplio uso obliga a recurrir a otros de último recurso, a menudo costosos, o de difícil acceso en los países en desarrollo.
Una de las pocas noticias positivas del estudio es que cada vez más países están colaborando en él, con 104 países participantes en la última edición frente a solo 25 en 2016, aunque aún faltan por unirse un 48 % de las redes sanitarias de los Estados miembros de la OMS.
Consecuencias de la salida de EEUU
La organización insiste en que una de las claves para combatir este fenómeno es abstenerse de usar antibióticos para cualquier infección bacteriana.
“Los pacientes no deben pensar que tener fiebre es ya una razón para recibir un antibiótico, y deben confiar en su médico o profesional sanitario”, destacó al presentar los datos el director del Departamento de Resistencia Antimicrobiana de la OMS, Yvan Hutin.
Las vacunas y normas sencillas de higiene, como el frecuente lavado de manos, son otras armas para prevenir las infecciones bacterianas, recordó.
La OMS subraya que sus problemas financieros actuales (fruto entre otros factores de la salida de Estados Unidos de la organización) han obligado a reducir el personal de la agencia encargado de estudiar la resistencia antimicrobiana.
Otra mala noticia para la lucha contra esta amenaza sanitaria es la reciente clausura del Fleming Fund, importante iniciativa del Reino Unido en este campo.